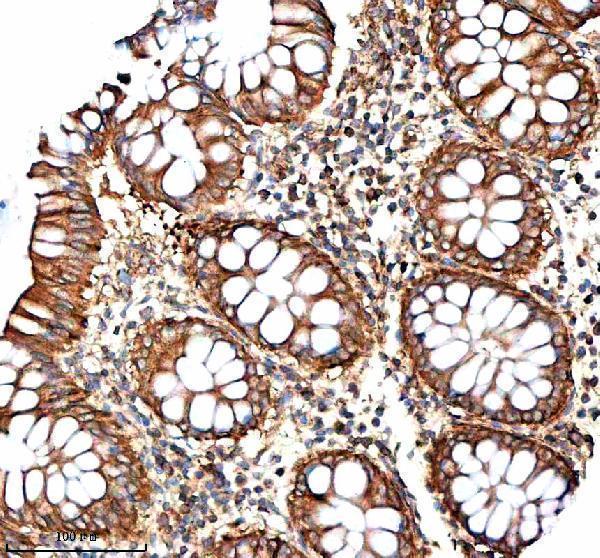
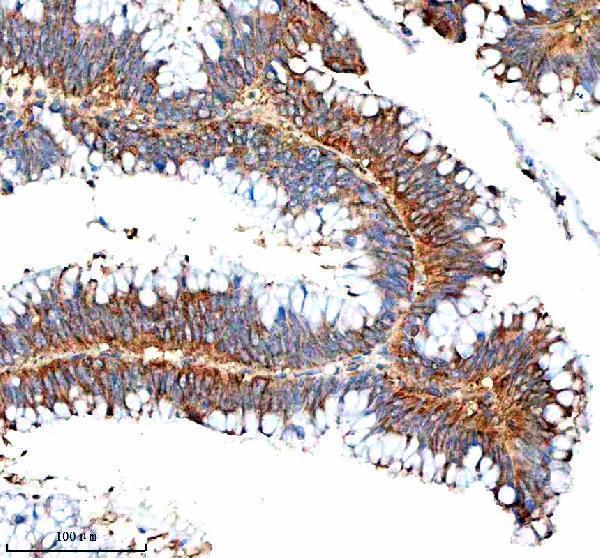

Filteroptionen
Kategorien
Antibody Type
Spezies-Reaktivität
- all (7)
- aves (17)
- bacteria (29)
- bovine (1)
- fish (2)
- gallus (1)
- human (223)
- monkey (2)
- mouse (131)
- other (55)
- rabbit (2)
- rat (33)
- virus (2361)
Wirt
- camelus (7)
- chimeric (3)
- chinese hamster (10)
- culture (2)
- feline (20)
- ferret (12)
- gallus (12)
- goat (382)
- hamster (1)
- human (224)
- mammal (8)
- mouse (2482)
- multiple (5)
- rabbit (2367)
- rat (4)
Markierung
- AE (36)
- AP (50)
- APC (86)
- APC/Cy5.5 (39)
- APC/Cy7 (39)
- Alexa Fluor 488 (1)
- Alexa Fluor 647 (1)
- BF350 (39)
- BF405 (39)
- BF488 (39)
- BF555 (39)
- BF594 (39)
- BF647 (39)
- BF680 (39)
- BF700 (28)
- BF750 (39)
- Biotin (189)
- Cy3 (42)
- Cy5 (39)
- Cy5.5 (39)
- Cy7 (39)
- FITC (172)
- Fluoro488 (2)
- Fluoro550 (2)
- Fluoro594 (2)
- Fluoro647 (2)
- HRP (191)
- IRDye800 (27)
- Magnetic Beads (1)
- PE (95)
- PE/Cy5 (37)
- PE/Cy5.5 (37)
- PE/Cy7 (37)
- Pacific Blue (28)
- PerCP (39)
- PerCP/Cy5.5 (39)
- PerCP/Cy7 (28)
- RBITC (39)
- Unconjugated (1669)
Hersteller
- ARP American Research Products (1)
- Abbexa (141)
- Abcepta (32)
- Abeomics (54)
- Abnova (110)
- Absolute Antibody (206)
- AcroBiosystems (58)
- Alpha Diagnostic (19)
- Antibodies.com (126)
- Assay Biotechnology (2)
- Aviva (31)
- BT Lab (2)
- Bio X Cell (2)
- Biomatik Corporation (3)
- Biorbyt (1407)
- Bioss (304)
- Biosynth (107)
- Bioworld Technology (16)
- Boster Bio (24)
- Cedarlane (27)
- Cloud-Clone (4)
- Covalab (23)
- Creative Biolabs (222)
- Cusabio (18)
- EastCoast Bio (29)
- GeneTex (200)
- ICL (2)
- Kerafast (33)
- Leadgene Biomedical (15)
- LifeSpan Biosciences (991)
- Linaris (21)
- MABTECH (4)
- MBL (2)
- MedchemExpress (2)
- Monosan (1)
- MyBiosource (1033)
- NSJ Bioreagents (1)
- NeoBiotechnologies (9)
- Neuromics (1)
- Nordic BioSite (72)
- NordicMubio (1)
- Phosphosolutions (1)
- ProSci (52)
- ProSpec-Tany Technogene (9)
- ProteoGenix (40)
- RayBiotech (62)
- Rockland Immunochemicals (19)
- Sceti (6)
- Sino Biological (1477)
- Statens Serum Institut (16)
- The Native Antigen Company (18)
- US Biological (818)
- ViroStat (39)
Isotyp
- f(ab)2 (3)
- iga (4)
- iga2 (2)
- igg (38)
- igg-fc fusion (2)
- igg1 (997)
- igg1 / kappa (4)
- igg1-fc fusion (4)
- igg2 (23)
- igg2a (551)
- igg2a / kappa (12)
- igg2b (413)
- igg2b kappa (2)
- igg3 (24)
- igm (45)
- scfv fragment (his) (6)
Klon-Bezeichnung
- [006] (2)
- [010] (3)
- [014] (2)
- [016] (5)
- [02] (3)
- [07-4b03] (1)
- [082] (2)
- [1.b.408] (8)
- [1.b.413] (2)
- [1.b.415] (2)
- [101] (1)
- [104] (2)
- [105] (1)
- [1078] (2)
- [107] (2)
- [108] (2)
- [10] (3)
- [10b8] (2)
- [10c5e11] (1)
- [10c5f12] (1)
- [10c6] (1)
- [10d14] (1)
- [10d15] (1)
- [10d16] (1)
- [10d17] (1)
- [10d267] (2)
- [10d281 inb4] (9)
- [10d281] (2)
- [10d282 b114] (9)
- [10f4] (1)
- [10h9] (1)
- [1114] (2)
- [111] (3)
- [1131 2b2] (5)
- [1131] (4)
- [1161] (3)
- [1171] (3)
- [1181] (3)
- [119] (2)
- [11a9] (1)
- [11e228] (1)
- [11f8] (2)
- [11h7] (2)
- [11h94] (1)
- [11h95] (1)
- [11h96] (1)
- [12ca5] (2)
- [13-9] (1)
- [1331] (11)
- [1341] (10)
- [1343] (1)
- [1361] (3)
- [1371] (3)
- [1381] (3)
- [13b419] (1)
- [13b420] (1)
- [13d4] (1)
- [13h286] (9)
- [13l13] (1)
- [13l14] (1)
- [13l15] (1)
- [13l16] (1)
- [13l17] (1)
- [13l19] (1)
- [13l2] (1)
- [13l3] (1)
- [13l4] (1)
- [14-12] (1)
- [14b11] (2)
- [14c2] (1)
- [14d105] (6)
- [15-12] (1)
- [15a6] (2)
- [15b385] (9)
- [15b386] (9)
- [15b387] (9)
- [15b388] (9)
- [15b389] (9)
- [15b390] (9)
- [15b391] (9)
- [15b393] (9)
- [15b394] (9)
- [15b395] (9)
- [15b396] (9)
- [15b398] (1)
- [15b399] (1)
- [15b400] (9)
- [15b401] (9)
- [15b402] (9)
- [15b403] (9)
- [15b404] (9)
- [15b405] (9)
- [15b406] (9)
- [15b407] (9)
- [15b408] (9)
- [15b409] (9)
- [15b410] (9)
- [15b411] (9)
- [15b412] (9)
- [15b413] (9)
- [15b414] (9)
- [15b546] (1)
- [15b548] (1)
- [15b549] (1)
- [15b551] (1)
- [15b552] (1)
- [15b554] (1)
- [15b556] (1)
- [15b557] (1)
- [15b558] (1)
- [15b559] (1)
- [15b560] (1)
- [15b561] (1)
- [15b562] (1)
- [15b563] (1)
- [15b565] (1)
- [16.43] (10)
- [16f6] (2)
- [16k188] (1)
- [16k189] (1)
- [16k190] (1)
- [16k191] (1)
- [16k192] (1)
- [16k193] (1)
- [16k194] (1)
- [16k195] (1)
- [16k196] (1)
- [16k197] (1)
- [16k198] (1)
- [16k199] (1)
- [16k200] (1)
- [17e81] (1)
- [17e82] (1)
- [17e83] (1)
- [17e84] (1)
- [18f337] (1)
- [18f338] (1)
- [18f339] (1)
- [18f340] (1)
- [18f341] (1)
- [18f342] (1)
- [18f343] (1)
- [18f346] (1)
- [18f347] (1)
- [18f348] (1)
- [18f349] (1)
- [18f350] (1)
- [19c10] (2)
- [19g6] (1)
- [1a12] (1)
- [1a256] (1)
- [1a257] (1)
- [1a258] (1)
- [1a259] (1)
- [1a260] (1)
- [1a261] (1)
- [1a2a11] (33)
- [1a8] (1)
- [1a9] (2)
- [1b1] (1)
- [1b4] (4)
- [1b6] (3)
- [1b8] (1)
- [1c2] (2)
- [1c7 1b4] (6)
- [1c7] (4)
- [1d10] (1)
- [1d3] (1)
- [1d6] (2)
- [1d8] (3)
- [1e01] (1)
- [1e6a7] (2)
- [1e7d8] (2)
- [1f7] (1)
- [1f8] (1)
- [1g01] (2)
- [1g04] (1)
- [1g6] (1)
- [1h11 6b5 9a9 9f2 10c6 10h9, new mabs: ina331 ina334 ina414] (6)
- [1h11] (2)
- [1h12] (2)
- [1h7a] (7)
- [2-12c] (18)
- [2-8c] (18)
- [2/3] (2)
- [22d11] (2)
- [22d7] (2)
- [22f12] (1)
- [245] (2)
- [274] (2)
- [2b3] (1)
- [2b8] (1)
- [2c7] (1)
- [2d6] (1)
- [2d8] (1)
- [2e5] (1)
- [2f10e12g1] (3)
- [2f1a7] (2)
- [2f205] (2)
- [2f3] (1)
- [2f4] (2)
- [2f5] (1)
- [2f8] (1)
- [2g2] (27)
- [2h6] (2)
- [2h7] (1)
- [2q1997] (2)
- [2q1998] (9)
- [2q2000 30-2f11-f7-a5] (9)
- [2q2002 9b3.2] (1)
- [2q2003 22d5-12-13] (9)
- [2q2003] (22)
- [3-10b] (14)
- [30-2f11-f7-a5] (7)
- [310-18a3] (12)
- [3a1] (1)
- [3b7] (2)
- [3b8] (1)
- [3c12] (1)
- [3c4] (1)
- [3c6] (1)
- [3c9] (1)
- [3d2] (1)
- [3d7] (7)
- [3e9] (2)
- [3e9h5] (1)
- [3f2] (1)
- [3f3] (2)
- [3f6] (1)
- [3g2] (1)
- [3g4] (1)
- [3h2461 aa5h] (9)
- [3h2461] (2)
- [3h2462 ga2b] (9)
- [3h2462] (3)
- [3h2463] (33)
- [3h5] (1)
- [3l3 2b2] (9)
- [405h1.01] (4)
- [41] (2)
- [431] (2)
- [4a2] (2)
- [4a8] (1)
- [4b11] (1)
- [4b1] (21)
- [4b9] (1)
- [4c2] (1)
- [4d4] (1)
- [4d5] (2)
- [4d9] (1)
- [4e10c10] (2)
- [4e11e1] (3)
- [4e6] (1)
- [4f1f2] (2)
- [4g1] (1)
- [4g6] (1)
- [4g8] (1)
- [4h1c10] (2)
- [50f9] (3)
- [58ab7-19-18] (5)
- [58ce8-1-5] (9)
- [5a1] (1)
- [5b2] (1)
- [5c10-g2] (2)
- [5c1] (2)
- [5c3] (1)
- [5c8] (1)
- [5d8] (3)
- [5e355] (11)
- [5e356] (9)
- [5e357] (2)
- [5e358] (1)
- [5e359] (1)
- [5e360] (1)
- [5e5] (1)
- [5e676] (6)
- [5f11] (1)
- [5g8] (1)
- [603] (1)
- [657] (2)
- [6a11] (2)
- [6a1] (1)
- [6b2] (1)
- [6b5] (1)
- [6b9] (1)
- [6e4c4] (1)
- [6e8] (1)
- [6f4c8] (1)
- [703] (4)
- [7304] (3)
- [7305] (3)
- [7307] (3)
- [7b4g10g8] (3)
- [7b9b2] (3)
- [7d8] (1)
- [7e7] (1)
- [7f8] (1)
- [7g2] (1)
- [7g45 4f1f2] (9)
- [7g45] (2)
- [7g46] (11)
- [7g47] (3)
- [7g48] (3)
- [7g49] (2)
- [7g4] (1)
- [7g5] (1)
- [7h12f6] (1)
- [8-5] (1)
- [8.f.182] (9)
- [8a10d8] (2)
- [8a1] (1)
- [8b5] (1)
- [8b6] (1)
- [8c8] (2)
- [8d1b9] (3)
- [8d3] (1)
- [8e3.c2] (5)
- [8e5] (1)
- [8g2] (2)
- [8g9] (1)
- [8h5 recomb] (1)
- [8h5] (17)
- [8j101] (8)
- [8j102] (18)
- [8j103] (6)
- [8j104] (18)
- [8j105] (18)
- [8j106] (18)
- [8j107] (18)
- [8j108] (6)
- [8j109] (6)
- [8j110] (6)
- [8j111] (18)
- [8j123] (1)
- [8j198] (6)
- [8j90] (18)
- [8j91] (18)
- [8j92] (6)
- [8j93] (6)
- [8j94] (1)
- [910] (2)
- [9901] (3)
- [9906] (3)
- [9909] (3)
- [9a9] (1)
- [9b69] (12)
- [9b70] (6)
- [9b71] (6)
- [9b72b] (8)
- [9c10b4] (2)
- [9c11] (7)
- [9c1] (1)
- [9c2] (1)
- [9d2] (1)
- [9f2] (1)
- [9g1g8] (3)
- [9g8] (2)
- [9l367] (8)
- [9l369] (6)
- [9l370] (6)
- [a1 & a3] (5)
- [a1 + a3] (1)
- [a1&a3] (1)
- [a1] (2)
- [a1igg2a & a3 igg1 2q1997] (1)
- [a65] (5)
- [aa5h] (12)
- [anp-vhh1] (6)
- [at1b7] (7)
- [at1g7] (8)
- [at2b7] (10)
- [av.c4] (13)
- [av.d1] (7)
- [av.g4] (7)
- [b017 b35g] (9)
- [b10] (1)
- [b114] (6)
- [b1273m] (1)
- [b1274m] (2)
- [b1275m] (2)
- [b14] (2)
- [b164] (2)
- [b193m] (2)
- [b198m] (2)
- [b19] (2)
- [b200m] (2)
- [b205m] (2)
- [b213m] (1)
- [b217m] (1)
- [b218m] (1)
- [b219m] (1)
- [b247m] (1)
- [b248m] (1)
- [b249m] (1)
- [b252m] (1)
- [b253m] (1)
- [b254m] (1)
- [b256m] (1)
- [b259m] (1)
- [b262m] (1)
- [b263m] (1)
- [b264m] (1)
- [b265m] (2)
- [b267m] (2)
- [b268m] (2)
- [b269m] (1)
- [b272m] (2)
- [b273m] (2)
- [b274m] (1)
- [b275m] (1)
- [b276m] (1)
- [b312m] (1)
- [b313m] (1)
- [b3191m] (1)
- [b3323m] (1)
- [b3] (2)
- [b467m] (1)
- [bdi016] (2)
- [bdi081] (2)
- [bdi107] (2)
- [bdi365] (2)
- [bdi375] (2)
- [bdi385] (2)
- [blend of b2 and b4] (1)
- [bs771] (1)
- [bs772] (1)
- [bs781] (1)
- [bs782] (1)
- [c102 iv.c102] (3)
- [c102] (13)
- [c3g6] (1)
- [c43] (4)
- [cd3g-0409] (2)
- [ch65] (2)
- [cr12042] (1)
- [cr12044] (1)
- [cr6261] (12)
- [cr8020] (6)
- [crb082] (1)
- [crb084] (1)
- [crb085] (1)
- [crb086] (1)
- [d04] (1)
- [da03e17] (1)
- [ebs-i-238] (3)
- [f045-092] (1)
- [f8, new mabs: ina108 ina245 ina180 ina224] (6)
- [f8] (2)
- [fab65] (1)
- [fld127] (4)
- [fld20] (4)
- [fld21.140] (1)
- [fld21] (8)
- [fld84] (4)
- [fld93] (4)
- [flu-5j8] (2)
- [flua-20] (2)
- [flua-np 2c9] (5)
- [flua-np 4f1] (8)
- [fluac] (6)
- [ft351] (1)
- [ga2b] (8)
- [gt1236] (1)
- [gt1653] (1)
- [gt172] (1)
- [gt1943] (1)
- [gt223] (1)
- [gt226] (1)
- [gt23] (1)
- [gt288] (1)
- [gt371] (2)
- [gt382] (2)
- [gt521] (1)
- [gt778] (1)
- [h011] (2)
- [h16-l10-4r5 hb-65] (2)
- [h16-l10-4r5 hb65] (1)
- [h7-235] (1)
- [h7.167] (1)
- [ha-1e10] (4)
- [ha.c5] (1)
- [ha22-c] (1)
- [ha68] (1)
- [hb65] (1)
- [hl1068] (1)
- [hl1069] (1)
- [hl1073] (1)
- [hl1076] (1)
- [hl1078] (1)
- [hl1089] (1)
- [hl1098] (1)
- [hl1103] (1)
- [hl1108] (1)
- [hl1273] (1)
- [hl1275] (1)
- [hl1321] (1)
- [hl1323] (1)
- [hl1342] (1)
- [hl1343] (1)
- [hl1387] (1)
- [hl1388] (1)
- [hl1476] (1)
- [hl1550] (1)
- [hl1559] (1)
- [hl1714] (1)
- [hl1715] (1)
- [hl1856] (1)
- [hl1952] (1)
- [hl1953] (1)
- [hl1992] (1)
- [hl1994] (1)
- [hl2130] (1)
- [hl2208] (1)
- [hl2393] (1)
- [hl2406] (1)
- [hl2408] (1)
- [hl3261] (1)
- [hl3262] (1)
- [hl4098] (1)
- [hl4504] (1)
- [hl4505] (1)
- [hl4607] (1)
- [hl4720] (1)
- [hl4724] (1)
- [hl4788] (1)
- [hl4873] (1)
- [hl4914] (1)
- [hl5074] (1)
- [ia-3808] (1)
- [ia-902] (1)
- [ia-h1n1] (4)
- [ia-h3n2] (8)
- [ia-h5n1] (8)
- [ia97-h1n1] (4)
- [ib-6334] (2)
- [ib42] (2)
- [ib633] (2)
- [if1a11] (13)
- [iha-h5n1-prs] (4)
- [ina108] (4)
- [ina134] (5)
- [ina139] (4)
- [ina180] (4)
- [ina224] (4)
- [ina227 ina246] (6)
- [ina227] (4)
- [ina245] (4)
- [ina246] (4)
- [ina331] (1)
- [ina334] (1)
- [ina4 ina16 ina88 ina97 ina134 ina139] (6)
- [ina414] (1)
- [ina4] (3)
- [ina88] (2)
- [ina97] (5)
- [inb114] (3)
- [inb12 inb27 inb36 inb64 inb114 inb204 inb210 inb213 2/3] (6)
- [inb12] (3)
- [inb15] (2)
- [inb18] (10)
- [inb190] (4)
- [inb204] (3)
- [inb210] (3)
- [inb213] (3)
- [inb27] (4)
- [inb36] (3)
- [inb4] (15)
- [inb64] (3)
- [it-1f9] (2)
- [iv f8] (1)
- [iv0146] (1)
- [iv0147] (1)
- [iv0148] (1)
- [iv0149] (1)
- [iv0150] (1)
- [ivc102] (1)
- [kan-1] (1)
- [m001] (2)
- [m01732] (2)
- [m02202] (2)
- [m11151] (2)
- [m11742] (2)
- [m12212] (2)
- [m18612ifa3] (2)
- [m18612ifa4] (2)
- [m18612ifa5] (2)
- [m18612ifa6] (2)
- [m18612ifa7] (2)
- [m2110169] (2)
- [m21161] (2)
- [m21752] (2)
- [m3072809] (2)
- [m3072810] (2)
- [m3072811] (2)
- [m31171] (2)
- [m31762] (2)
- [m32143] (2)
- [m322210] (2)
- [m322211] (1)
- [m4090912] (2)
- [m4090913] (2)
- [m4090914] (2)
- [m41181] (2)
- [m41772] (2)
- [m42131] (2)
- [m42245] (2)
- [m51191] (2)
- [m52246] (2)
- [m62151] (2)
- [m8121721] (2)
- [m8121722] (2)
- [m8121723] (2)
- [medi8852] (1)
- [mem5] (1)
- [mh001] (5)
- [mx1/7527] (4)
- [mx1/7529] (4)
- [mx1/7530] (4)
- [na-63] (1)
- [nc10] (1)
- [nc41] (1)
- [ns1-23-1] (8)
- [p52e03] (1)
- [pat1b7at] (4)
- [pat1g7at] (4)
- [pat2b7at] (4)
- [pib-633-hy] (8)
- [r2/3] (2)
- [s139] (1)
- [saa0410] (1)
- [saa0411] (1)
- [saa1023] (1)
- [saa1424] (1)
- [saa1425] (1)
- [saa1427] (1)
- [saa1442] (1)
- [saa2067] (1)
- [saa2266] (1)
- [saa2270] (1)
- [saa2308] (1)
- [saa2309] (1)
- [saa2408] (1)
- [saa2667] (1)
- [saa2701] (1)
- [t1-3b] (13)
- [tana2] (2)
- [v1131] (1)
- [v1161] (1)
- [v1171] (1)
- [v1181] (1)
- [v1331] (1)
- [v1371] (1)
- [vhh1] (1)
- [vis410] (1)
Applikation
- AGG (7)
- Activation (1)
- Activity Assay (2)
- BLI (15)
- Blocking (20)
- CLIA (22)
- Crystallography (6)
- DOT (4)
- EIA (80)
- ELISA (2276)
- EM (7)
- FA (10)
- FACS (8)
- FC (278)
- FLISA (290)
- FociSpot (8)
- GICA (6)
- HAI (77)
- HI (11)
- IA (3)
- IB (1)
- ICA (27)
- ICC (803)
- IF (1872)
- IFA (1)
- IH-Fr (13)
- IHC (464)
- IHC-Fr (178)
- IHC-P (388)
- IP (236)
- In vivo (8)
- LF (188)
- Multiplex Assay (1)
- NTRL (12)
- NeA (38)
- Nephelometry (1)
- RIA (8)
- SBR (15)
- WB (1769)
- neutralisation assays (12)
Influenza A, Nucleoprotein Antibody [FluA-NP 4F1], IgG1, Unconjugated, Mouse, Monoclonal
- Bilder: 2
- Applikation: 1
| Artikelnummer: | PRS-99-734 |
| Hersteller: | ProSci |
| Applikation: | FC |
| Kategorie: | Antikörper |
| Menge: | 0.5 mg |
| Preise anzeigen | |


(2) Bilder
Anti-IVNS1ABP Antibody Picoband, Rabbit, Polyclonal
- Bilder: 11
- Applikation: 6
| Artikelnummer: | BOB-A10942-2 |
| Hersteller: | Boster Bio |
| Applikation: | ELISA, FC, ICC, IF, IHC, WB |
| Kategorie: | Antikörper |
| Menge: | 100 µg |
| Preise anzeigen | |











(11) Bilder
Anti-IVNS1ABP Antibody Picoband, Rabbit, Polyclonal
- Bilder: 11
- Applikation: 6
| Artikelnummer: | BOB-A10942-2-CARRIER-FREE |
| Hersteller: | Boster Bio |
| Applikation: | ELISA, FC, ICC, IF, IHC, WB |
| Kategorie: | Antikörper |
| Menge: | 100 µg |
| Preise anzeigen | |

(11) Bilder
HA Tag Antibody, Unconjugated, Rabbit, Polyclonal
- Bilder: 1
- Applikation: 2
| Artikelnummer: | CSB-PA275079 |
| Hersteller: | Cusabio |
| Applikation: | ELISA, WB |
| Kategorie: | Antikörper |
| Menge: | 100 ul, 50 ul |
| Preise anzeigen | |

(1) Bilder
MX1 Antibody, Unconjugated, Rabbit, Polyclonal
- Bilder: 1
- Applikation: 2
| Artikelnummer: | CSB-PA616832 |
| Hersteller: | Cusabio |
| Applikation: | ELISA, WB |
| Kategorie: | Antikörper |
| Menge: | 100 ul, 50 ul |
| Preise anzeigen | |

(1) Bilder
MX2 Antibody, Unconjugated, Rabbit, Polyclonal
- Bilder: 1
- Applikation: 2
| Artikelnummer: | CSB-PA931467 |
| Hersteller: | Cusabio |
| Applikation: | ELISA, WB |
| Kategorie: | Antikörper |
| Menge: | 100 ul |
| Preise anzeigen | |

(1) Bilder
anti-Influenza A Antibody (Mouse - Clone 101), IgG1, Clone: [101], Monoclonal
- Bilder: 1
- Applikation: 2
| Artikelnummer: | ICL-MFZA-55A-101 |
| Hersteller: | ICL |
| Applikation: | ELISA, LF |
| Kategorie: | Antikörper |
| Menge: | 1 mg |
| Preise anzeigen | |

(1) Bilder
anti-Influenza A Antibody (Mouse - Clone 105), IgG1, Clone: [105], Monoclonal
- Bilder: 1
- Applikation: 2
| Artikelnummer: | ICL-MFZA-55A-105 |
| Hersteller: | ICL |
| Applikation: | ELISA, LF |
| Kategorie: | Antikörper |
| Menge: | 1 mg |
| Preise anzeigen | |

(1) Bilder
Anti-influenza B (NP) mAb (4D5), unconjugated, IgG1, Unconjugated, Mouse
- Bilder: 1
- Applikation: 2
| Artikelnummer: | MAB-4406-5-100 |
| Hersteller: | MABTECH |
| Applikation: | ELISA, FociSpot |
| Kategorie: | Antikörper |
| Menge: | 100 µg |
| Preise anzeigen | |

(1) Bilder
Anti-influenza B (NP) mAb (4D5), biotin, IgG1, Biotin, Mouse
- Bilder: 1
- Applikation: 2
| Artikelnummer: | MAB-4406-6-100 |
| Hersteller: | MABTECH |
| Applikation: | ELISA, FociSpot |
| Kategorie: | Antikörper |
| Menge: | 100 µg |
| Preise anzeigen | |

(1) Bilder




 Ein typischer Immunassay wird zunächst mit einem Blocking-Reagenz inkubiert um unspezifische Bindungen zu minimieren. Anschließend wird der primäre Antikörper hinzugefügt, der spezifisch an das Ziel-Antigen bindet. Nach dem Auswaschen etwaiger ungebundener Antikörper, wird ein Sekundärantikörper zur Detektion verwendet. Sekundärantikörper sind meist Anti-Spezies-Antikörper gegen den Wirt, in welchem der Primärantikörper generiert wurde, und üblicherweise mit einem Farbstoff oder Enzym gekoppelt, um die Anwesenheit des detektierten Antigens in der Probe sichtbar zu machen.
Ein typischer Immunassay wird zunächst mit einem Blocking-Reagenz inkubiert um unspezifische Bindungen zu minimieren. Anschließend wird der primäre Antikörper hinzugefügt, der spezifisch an das Ziel-Antigen bindet. Nach dem Auswaschen etwaiger ungebundener Antikörper, wird ein Sekundärantikörper zur Detektion verwendet. Sekundärantikörper sind meist Anti-Spezies-Antikörper gegen den Wirt, in welchem der Primärantikörper generiert wurde, und üblicherweise mit einem Farbstoff oder Enzym gekoppelt, um die Anwesenheit des detektierten Antigens in der Probe sichtbar zu machen. 


